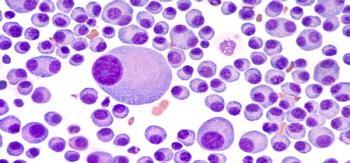

Belantamab mafodotin is a B-cell maturation antigen-targeting antibody-drug conjugate being investigated in the treatment of multiple myeloma.
Belantamab mafodotin is a B-cell maturation antigen-targeting antibody-drug conjugate being investigated in the treatment of multiple myeloma.

Delirium was the sixth most common presenting symptom in all patients, suggesting the clinical importance of including delirium on checklists of presenting signs and symptoms for COVID-19.

As the literature continues to develop, it will continue being important to rely on well-researched and relied-upon supportive care measures in critically patients.

The proportion of patients with hemophilia A receiving Hemlibra who experienced zero treated bleeds increased with each consecutive 24-week period.

AMG 701 is a bi-specific T-cell engager molecule being investigated for relapsed or refractory heavily pre-treated multiple myeloma.

Talquetamab is a bispecific antibody that binds to GPRC5D and CD3 to induce T cell-mediated killing of GPRC5D-expressing multiple myeloma cells.

Multiple myeloma is characterized by expression of the cell surface BCMA, making this a target for therapeutic intervention with REGN5458.

New research identifies patients most at risk of continuing problems with medulloblastoma, which can be applied immediately in medical clinics.

Study indicates pure CBD was able to reduce cell viability in 3 of the 6 cell lines and that this effect was cell line specific rather than specific to certain cancers.

According to the survey results, 56% of patients with chronic obstructive pulmonary disease reported that COVID-19 has made it difficult for them to receive treatment

Targeted therapies often have better toxicity profiles, allowing patients to remain adherent and stay on medications longer.

Following authorization allowing pharmacists to administer childhood vaccines, some pediatricians have expressed concerns that this deprives children of medical care or could lead to missed vaccines.

Warning letters requested that companies immediately stop selling these unapproved products and said consumers concerned about COVID-19 should talk to their health care provider.

The new optical sensing method is based on multi-pass spectroscopy and can detect the presence of 1 molecule of formaldehyde in a million air particles, or 1 part per million, even in the presence of gasses that often interfere with optical measurements.

Even when all 5 factors were optimally controlled, patients with type 2 diabetes still had a 21% higher risk for CVD and a 31% higher risk for heart failure hospitalization compared to patients without diabetes.

Moderna intends to submit the EUA application today and believes that the FDA’s Vaccines and Related Biological Products Advisory Committee will meet to review the safety and efficacy data package on Thursday, December 17, according to the press release.

Investigators found that participants with the healthiest sleep habits had a 42% reduction in the risk of heart failure compared to participants with an unhealthy sleep pattern.

Although cancer deaths with the highest death rates per capita accounted for the greatest number of years lost, the study authors said cancers that typically occur in younger populations had a disproportionate share of the burden.

According to the study results, women interested in medical cannabis reported marginally lower levels of support from their primary care provider and significantly less support from specialist physicians.

It can be administered as a fixed-dose formulation over approximately 3 to 5 minutes, which is significantly less time than the intravenous (IV) formulation.

Webinar participants discuss best practices for pharmacists with patients contending with both issues.

The companies expect to product up to 50 million doses globally before the end of 2020, and up to 1.3 billion doses by the end of 2021.

A genetically edited form of herpes simplex virus altered to prevent it from avoiding an immune response outperformed a leading vaccine candidate.

Although the number of beneficiaries increased between 2014 and 2018, total costs decreased.

By supplying proper PPE and infrastructure, health systems can keep workers safe and provide excellent patient care.

Researchers find that blue light exposure should be of concern to organizations, which may be able to improve employee performance by minimizing their exposure.

Although the announcement comes when many patients are trying to avoid unnecessary trips to stores or physicians’ offices, the offerings of Amazon will have a massive impact on traditional retail pharmacies.

With more awareness of the susceptibility to coinfection with varicella zoster virus and pneumocystic jirovecii, clinicians should aggressively seek signs of opportunistic infections in susceptible patients and treat them accordingly.

Prescriptions for evidence-based cancer drugs increased under a pay-for-performance program without significantly impacting cost of care.

Financial distress and disruptions to work and social activities were significantly associated with depression and anxiety, as well as generally diminished psychological wellbeing.